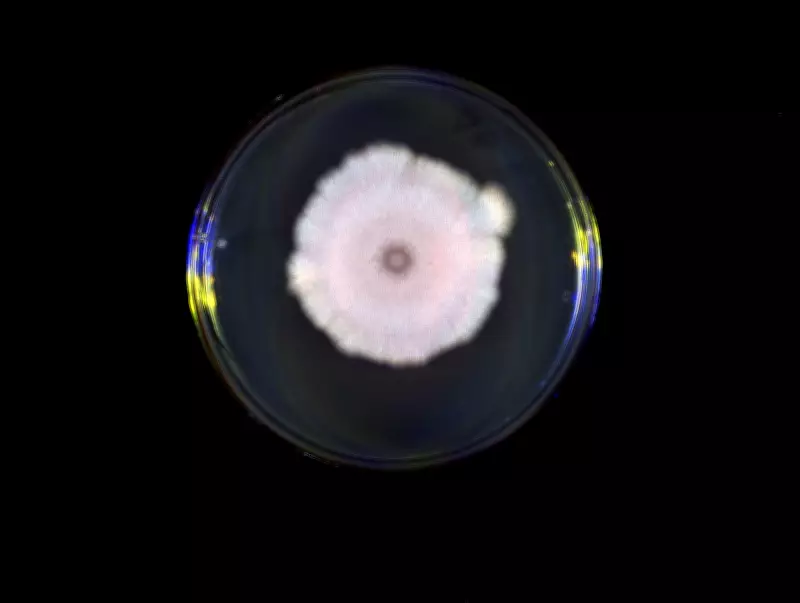

Vírus são capazes de 'escutar' conversas químicas de outras espécies, revela estudo inovador
Uma descoberta científica surpreendente publicada nesta terça-feira (31) na prestigiada revista Cell revela que os vírus possuem uma capacidade de comunicação mais complexa do que se imaginava. Pesquisadores da Universidade de Exeter, no Reino Unido, demonstraram que vírus são capazes de interceptar sinais químicos trocados por outras espécies virais, um fenômeno que pode levar a decisões estratégicas equivocadas com consequências significativas para seu sucesso infeccioso.
O sistema de arbitrium e a estratégia viral
Os vírus estudados são os chamados fagos, que infectam bactérias e são abundantemente encontrados no solo. Quando invadem uma célula bacteriana, esses vírus enfrentam uma decisão crucial:
- Opção 1: Matar a célula imediatamente, liberando cópias de si mesmos para infectar outras bactérias próximas
- Opção 2: Camuflar-se dentro do genoma bacteriano e aguardar condições mais favoráveis, em um estado chamado lisogenia
Para tomar essa decisão, alguns fagos utilizam um sofisticado sistema de comunicação química denominado arbitrium. Durante o processo de infecção, eles liberam pequenas moléculas no ambiente que funcionam como um verdadeiro termômetro da situação:
- Quando essas moléculas se acumulam, indicam que muitas células já foram infectadas e o estoque de hospedeiros está escasso
- Nesse cenário, a estratégia mais prudente é entrar em modo de espera
- Quando a concentração é baixa, sinalizando abundância de hospedeiros disponíveis, o caminho mais vantajoso é atacar imediatamente
A espionagem interespécies e suas consequências
O que o novo estudo revelou é que esses sinais químicos não ficam restritos aos vírus da mesma espécie. Outros fagos, mesmo geneticamente distantes do emissor original, conseguem captar essas mensagens e responder a elas, mesmo quando o sinal não foi produzido para eles e não reflete com precisão a situação em que se encontram.
"Quando um fago detecta sinais de outra espécie, ele tende a entrar em dormência em vez de matar a célula e liberar novos vírus, mesmo que a mensagem não tenha sido feita para ele e não reflita sua própria situação", explicou a ecologista molecular Robyn Manley, da Universidade de Exeter e autora principal do estudo.
Esse fenômeno de espionagem interespécies pode levar a decisões estratégicas custosas:
- Vírus que escolhem a lisogenia quando deveriam atacar perdem oportunidades valiosas de replicação
- Vírus que atacam quando não há hospedeiros suficientes produzem cópias que não encontram destino e acabam destruídas
- O erro na tomada de decisão pode comprometer seriamente o sucesso infeccioso do vírus
Manipulação viral e implicações mais amplas
A pesquisa identificou ainda que a espionagem pode, em certos casos, ser vantajosa para o vírus que emitiu o sinal original. Quando um fago já está integrado ao genoma bacteriano em estado de dormência, ele pode se beneficiar se outro vírus recém-chegado "ouvir" seus sinais e optar por também entrar em dormência, em vez de destruir a célula que abriga ambos.
"Isso pode beneficiar o vírus que enviou o sinal, pois impede que outro vírus mate as células, mas pode ter um custo para o vírus que responde", detalhou Manley. "Em outras palavras, a comunicação viral não é apenas cooperação. Às vezes, é manipulação."
O sistema de comunicação por arbitrium foi descrito pela primeira vez em 2017, mas o novo estudo avança significativamente ao demonstrar que essa comunicação extrapola as fronteiras da espécie com consequências imprevisíveis para a dinâmica das infecções.
Implicações para vírus que infectam humanos
Embora os experimentos tenham sido realizados com fagos e bactérias do gênero Bacillus, comuns no solo, as implicações da descoberta podem alcançar outros sistemas biológicos. Muitos vírus que infectam humanos também alternam entre fases ativas e dormentes, como é o caso do vírus do herpes simples, capaz de permanecer latente por longos períodos antes de se reativar.
"Possivelmente existem sistemas semelhantes em vírus que infectam humanos", afirmou Manley. "Compreender como os vírus decidem quando se ativar ou permanecer dormentes é central para prever a dinâmica das doenças."
Os próximos passos da equipe de pesquisa incluem investigar quão disseminadas são essas interações entre espécies virais e como elas se comportam em ambientes mais complexos, próximos das condições reais encontradas na natureza, longe do controle rigoroso do laboratório. O objetivo final é construir uma visão mais completa de como os vírus se comportam em comunidade, não isoladamente, abrindo novas perspectivas para a compreensão das dinâmicas infecciosas e possíveis intervenções terapêuticas.









